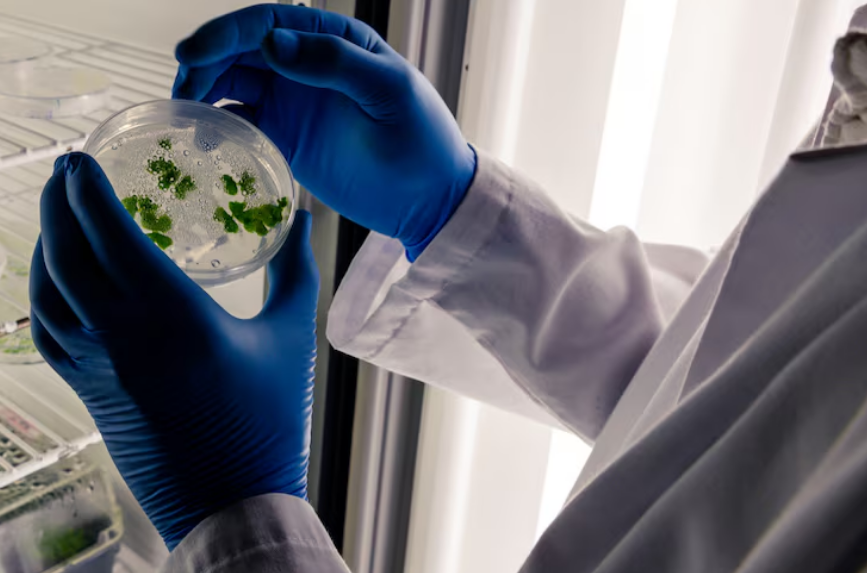

A microbiologia ambiental estuda os microrganismos que habitam solo, água, ar e organismos vivos, e sua interação com o meio ambiente.
Com as mudanças climáticas acelerando, esses seres invisíveis estão no centro de uma revolução: enquanto alguns micróbios agravam crises ambientais, outros podem ser a chave para soluções sustentáveis.
Neste artigo, você vai descobrir como bactérias, fungos e vírus influenciam (e são influenciados) pelo aquecimento global, inovações estão surgindo e por que essa área é tão importante para o futuro do planeta.
- Quais são as principais mudanças climáticas atualmente?
- O impacto das mudanças climáticas na biodiversidade microbiana
- Microbioma do solo e mudanças climáticas
- Microorganismos marinhos e acidificação dos oceanos
- Patógenos emergentes e mudanças climáticas
- Microorganismos e desastres naturais
- Tecnologias microbianas para mitigação das mudanças climáticas
Quais são as principais mudanças climáticas atualmente?
 As mudanças climáticas não são um problema distante; no Brasil, os efeitos já são visíveis. Nos últimos 50 anos, a temperatura média no país aumentou 1,5°C, de acordo com o Instituto de Pesquisa Econômica Aplicada (Ipea), trazendo diversas consequências. Um dos impactos notáveis são os eventos climáticos extremos, como secas, enchentes e queimadas por todo o país.
As mudanças climáticas não são um problema distante; no Brasil, os efeitos já são visíveis. Nos últimos 50 anos, a temperatura média no país aumentou 1,5°C, de acordo com o Instituto de Pesquisa Econômica Aplicada (Ipea), trazendo diversas consequências. Um dos impactos notáveis são os eventos climáticos extremos, como secas, enchentes e queimadas por todo o país.
Além disso, a acidificação dos oceanos, causada pelo aumento da concentração de dióxido de carbono na atmosfera, resultou na redução do pH da água do mar, afetando a vida marinha costeira. Essa mudança no pH altera a composição química dos oceanos, dificultando a sobrevivência de organismos marinhos como corais e moluscos.
Outro efeito preocupante é o de gelo polar, particularmente na Antártida, que desde os anos 90 vem perdendo toneladas de gelo. O derretimento das calotas polares contribui para o aumento do nível do mar, afetando comunidades costeiras e ecossistemas em todo o mundo.
- Essas transformações impactam diretamente os ecossistemas microbianos, que desempenham um papel importante na regulação de ciclos biogeoquímicos essenciais, como o do carbono e do nitrogênio.
Assim, microrganismos do solo e dos oceanos são responsáveis pela decomposição de matéria orgânica e pela fixação de nitrogênio, processos fundamentais para a manutenção da vida na Terra. As alterações climáticas podem desequilibrar esses ciclos, causando efeitos em cadeia nos ecossistemas e na biodiversidade global.
“As mudanças climáticas são transformações a longo prazo nos padrões de temperatura e clima.”
O impacto das mudanças climáticas na biodiversidade microbiana
Microbioma do solo e mudanças climáticas
 O solo abriga um terço da biodiversidade terrestre, com microrganismos desempenhando papéis cruciais na decomposição de matéria orgânica e fixação de nutrientes.
O solo abriga um terço da biodiversidade terrestre, com microrganismos desempenhando papéis cruciais na decomposição de matéria orgânica e fixação de nutrientes.
Nesse sentido, microrganismos como bactérias e fungos são responsáveis por transformar matéria morta em nutrientes reutilizáveis, essenciais para a saúde das plantas e a manutenção dos ecossistemas.
No entanto, condições adversas como secas prolongadas podem reduzir a atividade das bactérias fixadoras de nitrogênio, comprometendo a fertilidade do solo. Essas bactérias são vitais para converter o nitrogênio atmosférico em formas que as plantas possam absorver e utilizar.
Sem essa fixação, as plantas têm menos acesso a um nutriente fundamental para o seu crescimento, o que pode levar a solos menos férteis e a uma menor produtividade agrícola.
Além disso, queimadas têm um impacto devastador nos fungos micorrízicos, que estabelecem uma relação simbiótica com as raízes das plantas, ajudando-as a absorver água e nutrientes do solo. Quando essas relações simbióticas são destruídas, as plantas perdem uma fonte essencial de suporte, dificultando sua sobrevivência e crescimento.
Um exemplo claro desse impacto é observado na Amazônia, onde bactérias do gênero Bradyrhizobium são essenciais para fixar o dióxido de carbono (CO₂). Essas bactérias vivem em simbiose com leguminosas, convertendo o nitrogênio do ar em nutrientes utilizáveis para as plantas e, simultaneamente, sequestrando CO₂.
No entanto, o declínio dessas bactérias devido ao desmatamento e às mudanças no uso da terra resultou na liberação de 20% mais carbono na atmosfera. Esse aumento nas emissões de carbono contribui significativamente para o aquecimento global, criando um ciclo vicioso de degradação ambiental e mudanças climáticas.
Esses exemplos ilustram como as interações complexas entre microrganismos e seu ambiente são fundamentais para a saúde do planeta, e como as mudanças ambientais podem ter efeitos em cascata sobre os ecossistemas.
“A Microbiologia Ambiental é uma área da ciência que se dedica ao estudo da fisiologia, genética, interações e funções dos microrganismos no ambiente, e faz uso deste conhecimento com o objetivo maior de manter a qualidade ambiental e contribuir para o desenvolvimento sustentável da sociedade moderna.”
Fonte: Microbiologia Ambiental
Microorganismos marinhos e acidificação dos oceanos
Fitoplânctons e cianobactérias marinhas são responsáveis pela produção de 50% do oxigênio da Terra, desempenhando um papel essencial na manutenção do equilíbrio dos ecossistemas aquáticos e atmosféricos. No entanto, as mudanças ambientais estão afetando gravemente esses organismos.
A acidificação dos oceanos, causada pelo aumento das concentrações de dióxido de carbono (CO₂) na atmosfera, reduz a capacidade de organismos, como algas, de sequestrar CO₂. Essas algas formam estruturas de carbonato de cálcio que ajudam a remover CO₂ da água, mas a diminuição do pH dificulta esse processo, comprometendo a capacidade do oceano de atuar como um sumidouro de carbono.
Além disso, o aquecimento das águas está provocando a proliferação de algas tóxicas, conhecidas como marés vermelhas. Elas liberam toxinas nocivas, que podem matar peixes e contaminar frutos do mar, representando um risco para a saúde humana e causando prejuízos econômicos significativos para a pesca e o turismo.
As marés vermelhas também podem criar zonas mortas, áreas onde a concentração de oxigênio é tão baixa que a vida marinha não consegue sobreviver.
Leia mais: Microbiologia: o que é? Para que serve? Como se especializar?
Mudanças climáticas e respostas microbianas mencionadas |
||
| Mudança citada | Impacto microbiano | Exemplos do texto |
|---|---|---|
| Acidificação dos oceanos | Menor sequestro de CO₂ por algas | Redução do pH e impacto em corais/moluscos |
| Aquecimento das águas | Proliferação de algas tóxicas | Marés vermelhas e zonas mortas |
| Secas prolongadas | Queda na fixação de nitrogênio | Menor fertilidade do solo |
| Queimadas | Perda de fungos micorrízicos | Prejuízo ao suporte das plantas |
Patógenos emergentes e mudanças climáticas
O aquecimento global está redefinindo a geografia de doenças de diversas maneiras. Os vetores estão se expandindo, como é o caso dos mosquitos Aedes aegypti, que agora avançam para regiões anteriormente frias, levando consigo doenças como dengue e chikungunya.
Esse avanço ocorre porque as temperaturas mais elevadas criam um ambiente propício para a reprodução desses mosquitos, aumentando a incidência dessas doenças em áreas que antes não eram afetadas.
Além disso, os ambientes mais quentes aceleram a mutação de patógenos, resultando em bactérias mais resistentes. Essas bactérias prosperam em águas mais quentes, aumentando o risco de infecções para as pessoas que frequentam essas áreas.
As zoonoses também estão em ascensão devido ao desmatamento e às temperaturas elevadas, que facilitam os saltos de vírus de animais para humanos. Nesse sentido, a destruição de habitats naturais força os animais a se aproximarem mais dos seres humanos, aumentando a possibilidade de transmissão de doenças zoonóticas.
Microorganismos e desastres naturais
Enchentes, furacões e incêndios têm um impacto dramático nos microbiomas. Durante enchentes urbanas, as chances de contaminação por leptospirose aumentam em pelo menos 10 vezes de acordo com a Organização Mundial da Saúde (OMS).
Enchentes, furacões e incêndios têm um impacto dramático nos microbiomas. Durante enchentes urbanas, as chances de contaminação por leptospirose aumentam em pelo menos 10 vezes de acordo com a Organização Mundial da Saúde (OMS).
Essa doença é transmitida pelo contato direto com a água contaminada, causando sintomas como febre alta, dor de cabeça e, em casos graves, complicações renais e hepáticas.
Após as queimadas, os esporos de fungos oportunistas como o Aspergillus se dispersam pelo ar, causando infecções pulmonares nos moradores que vivem próximo. Esses fungos aproveitam a debilidade do sistema respiratório após a inalação de fumaça e cinzas, levando a infecções que podem ser graves, especialmente em pessoas com imunidade comprometida.
Para mitigar os danos causados por desastres naturais, a reconstrução ecológica envolve o uso de micro-organismos benéficos para recuperar solos degradados. Eles melhoram a qualidade do solo, ajudando na decomposição de matéria orgânica e na fixação de nutrientes, promovendo a recuperação das áreas afetadas e a restauração da biodiversidade.
Tecnologias microbianas para mitigação das mudanças climáticas
A microbiologia ambiental também oferece soluções inovadoras. Um exemplo é a biorremediação, que utiliza microrganismos para descontaminar ambientes poluídos.
Assim, bactérias como a Pseudomonas putida são capazes de “consumir petróleo”, tornando-se uma ferramenta eficaz para limpar oceanos após vazamentos de óleo. Outro exemplo são os fungos que têm a capacidade de degradar plástico, como poliuretano, em questão de semanas, ajudando a combater a poluição plástica.
Na captura de carbono, cianobactérias geneticamente modificadas se destacam por sequestrar CO₂ 20 vezes mais rápido que árvores. Além disso, o biochar, um tipo de carvão produzido a partir de matéria orgânica, armazena carbono no solo, ajudando a reduzir a quantidade de CO₂ na atmosfera.
Em termos de energia sustentável, certas bactérias podem produzir hidrogênio a partir de resíduos orgânicos, oferecendo uma fonte limpa de energia. O biogás, composto principalmente de metano produzido em aterros sanitários, pode ser convertido em eletricidade, contribuindo para a geração de energia renovável.
“Um marco regulatório desse sistema é a Política Nacional sobre Mudança do Clima (PNMC), instituída pela Lei 12.187, de 29 de dezembro de 2009 (atualizada em 2010).”
Fonte: Mudanças climáticas
A microbiologia ambiental é uma área em ascensão, com papel duplo nas mudanças climáticas. Enquanto microrganismos patogênicos e desequilíbrios ecossistêmicos agravam crises, soluções como bioremediação e captura microbiana de carbono mostram que o futuro pode ser mais verde.
Se você quer se especializar nesse campo, conheça a pós-graduação EAD em microbiologia, uma oportunidade de unir ciência, inovação e impacto global.
FAQ
-
Qual a importância dos microrganismos para o clima?
Regulam ciclos do carbono e do nitrogênio, influenciando decomposição, sequestro de CO₂ e fertilidade de solos e oceanos.
-
Como o aquecimento dos oceanos afeta a saúde humana?
Favorece marés vermelhas e toxinas que contaminam peixes e frutos do mar, com impacto econômico e de saúde pública.
-
Que soluções a microbiologia ambiental oferece?
Biorremediação de poluentes, captura microbiana de carbono e bioenergia a partir de resíduos orgânicos.






